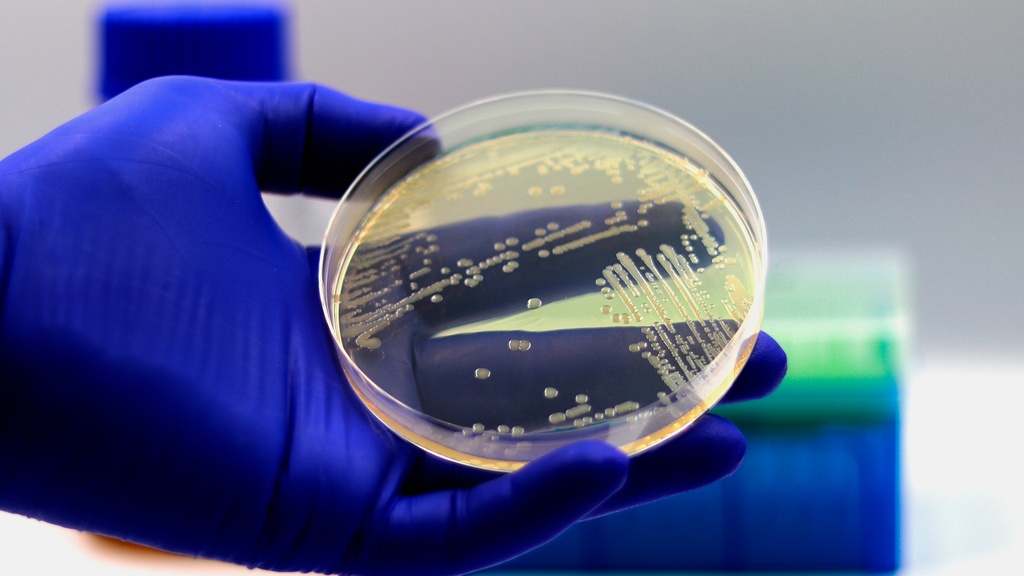
Coprocultivo Lapi Laboratorio Médico

El coprocultivo o cultivo de heces consiste en el cultivo de materia fecal. Es un método de diagnóstico microbiológico que permite identificar diferentes organismos causantes de enfermedades gastrointestinales.
Finalidad
Es indicado para el diagnóstico de ciertas infecciones del aparato gastrointestinal, especialmente aquellas infecciones provocadas por bacterias. Se utiliza para estudiar casos de diarrea severa, persistente o recurrente sin causas conocidas, y en caso de diarreas asociadas al consumo de antibióticos.
Modo a realizar
Toma de muestras
La materia fecal para coprocultivo debe estar libre de contaminantes como orina o papel higiénico. Se puede obtener la muestra recogiendo las heces en una bolsa plástica adosada a la taza del inodoro o utilizando equipos de recolección comerciales. En caso de bebés, se puede adosar la bolsa al pañal. Una vez obtenida la muestra se debe colocar en un recipiente estéril y derivarla al laboratorio lo más rápido posible.
Técnica de laboratorio
Se realiza una siembra de heces sobre una caja de Petri que contiene un medio de crecimiento. Se vigila el crecimiento, y en caso de existir microorganismos se les identifica mediante microscopía o empleo de tinciones específicas.
Exámenes complementarios
Por lo general, se realizan los siguientes exámenes para complementar el cultivo:
- Tinción de Gram en heces.
- Frotis fecal y parásitos.
- Sangre oculta.
Véase también
- Coprología
- Aparato gastrointestinal
- Bacterias
- Diarrea
- Materia fecal
Bibliografía
- DuPont HL. Approach to the patient with suspected enteric infection. In: Goldman L, Ausiello D, eds. Cecil Medicine. 23rd ed. Philadelphia, Pa: Saunders Elsevier; 2007: chap 305.
- Steiner TS, Guerrant RL. Principles and syndromes of enteric infection. In: Mandell GL, Bennett JE, Dolin R, eds. Principles and Practice of Infectious Diseases. 7th ed. Philadelphia, Pa: Elsevier Churchill Livingstone; 2009:chap 93.